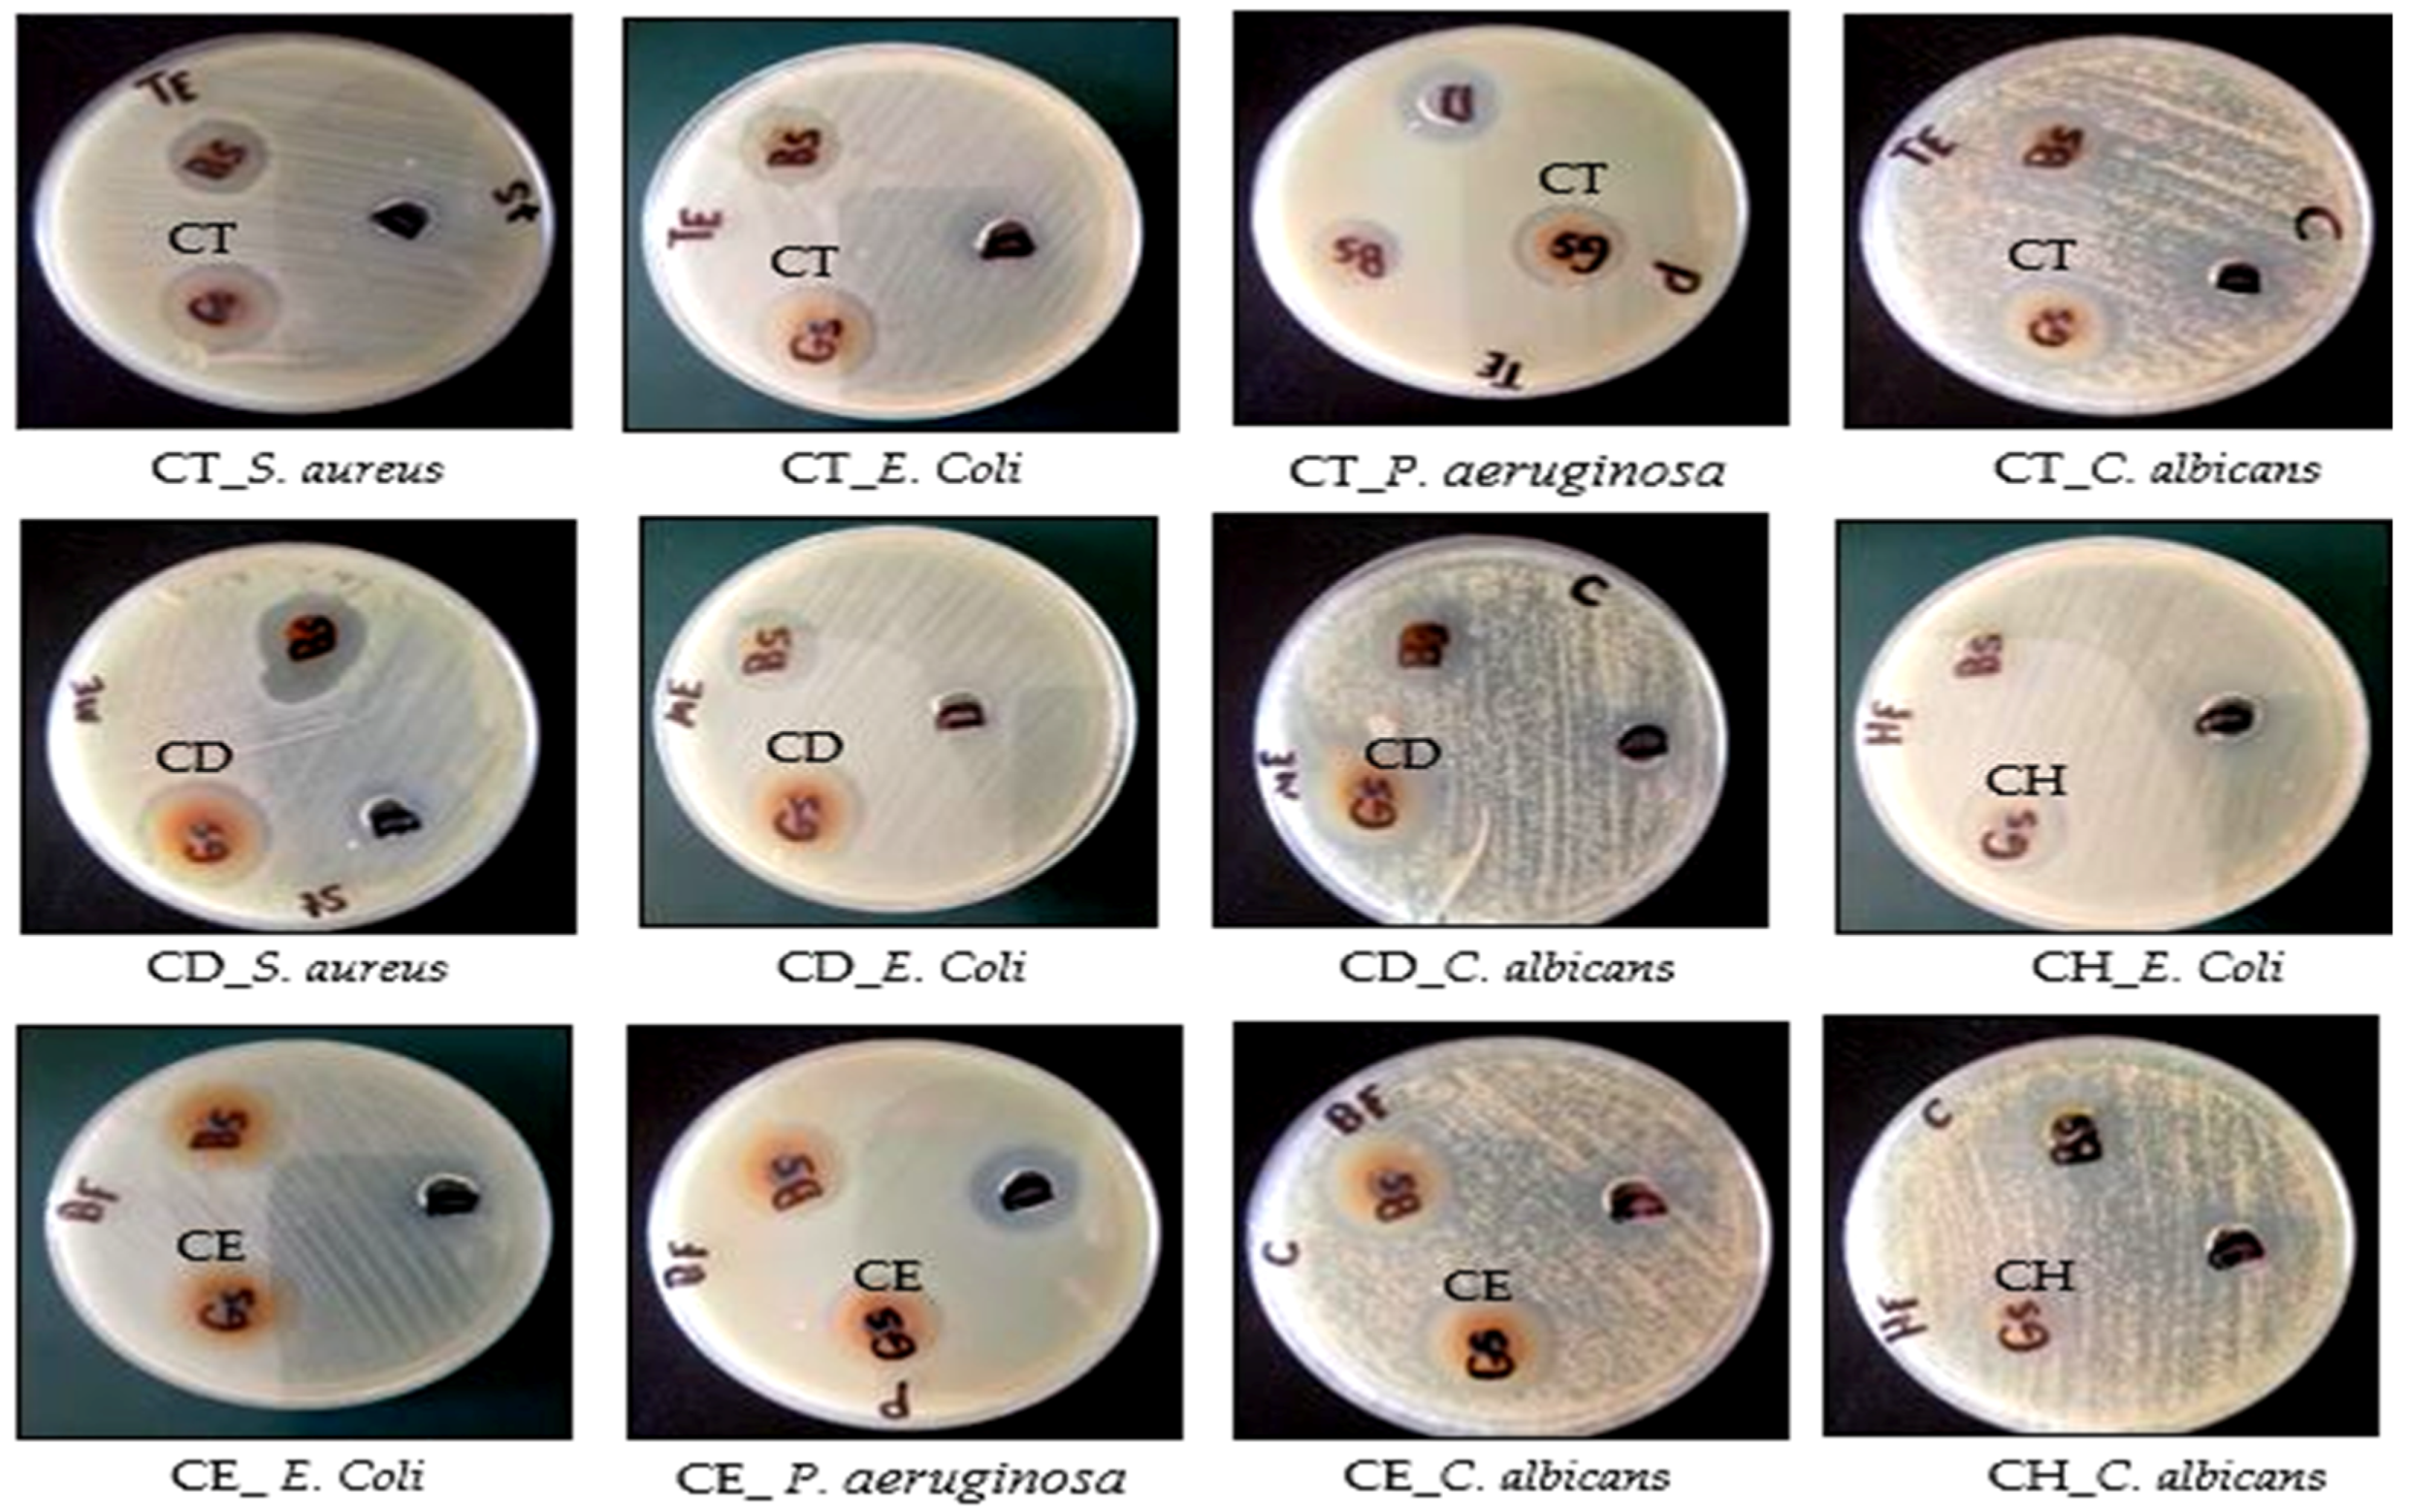
Molecules 28 01643 g009

Metabolites Profiling and In Vitro Biological Characterization of Different Fractions of Cliona sp. Marine Sponge from the Red Sea Egypt
Abstract
:1. Introduction
2. Results and Discussion
2.1. Characterization of the Isolated Compounds
2.2. Tentative Identification of Constituents of Cliona sp. Fractions by UPLC-ESI-MS/MS (Ultra-Performance Liquid Chromatography Electrospray Ionization Tandem Mass Spectrometry)
2.2.1. Characterization of the Components of Cliona sp. n-Hexane Fraction
2.2.2. Characterization of the Components of Cliona sp. Dichloromethane Fraction
| No. | Compound Name | Rt (min.) | Parent Ion (m/z) | MS2 Fragments (m/z) | Area % Total | Reference |
|---|---|---|---|---|---|---|
| 1 | Phosphorylethanolamine isomer | 0.14 | 142 [M + H]+ | 124, 110, 85, 82, 78, 69, 66, 55, 52 | 2.84 | [29] |
| 2 | Phosphorylethanolamine isomer | 0.23 | 142 [M + H]+ | 124, 110, 85, 82, 78, 69, 66, 55, 52 | 1.20 | [29] |
| 3 | Phosphorylethanolamine isomer | 0.31 | 142 [M + H]+ | 124, 110, 85, 82, 78, 69, 66, 55, 52 | 0.74 | [29] |
| 4 | Phosphorylethanolamine isomer | 0.41 | 142 [M + H]+ | 124, 110, 85, 82, 78, 69, 66, 55, 52 | 1.30 | [29] |
| 5 | N-methyl leucine | 0.48 | 146 [M + H]+ | 131, 87 | 3.38 | [26] |
| 6 | Asparagine | 0.55 | 133 [M + H]+ | 88, 73 | 2.84 | [26] |
| 7 | Asparagine isomer | 0.67 | 133 [M + H]+ | 88, 73 | 5.73 | [26] |
| 8 | Phosphorylethanol amine | 0.92 | 142 [M + H]+ | 124, 110, 85, 82, 78, 69, 66, 55, 52 | 5.06 | [26] |
| 9 | Gresiofulvin | 25.16 | 353 [M + H]+ | 21, 257, 215, 165 | 12.83 | [44] |
| 10 | β-Sitosterol | 28.66 | 397 [M + H-18]+ | 312 | 11.68 | [43] |
| 11 | Sphingomyelin derivative | 29.07 | 511 [M + H]+ | 184, 124, 104, 60 | 21.48 | [29] |
| 12 | Sphingomyelin derivative | 29.52 | 510 [M + H]+ | 184, 124, 104, 60 | 3.23 | [29] |
| 13 | Sphingomyelin derivative | 30.79 | 547 [M + H]+ | 487, 264, 147, 86 | 2.69 | [29] |
| 14 | Sphingomyelin derivative | 31.21 | 525 [M + H]+ | 184, 124, 104, 60 | 6.05 | [29] |
| 15 | Stigmasterol * | 35.35 | 395 [M + H-H2O] | 0.45 | [23] | |
| 16 | Sphingomyelin derivative | 35.67 | 593 [M + H]+ | 184, 124, 104, 60 | 2.31 | [45] |
2.2.3. Characterization of the Components of Cliona sp. Ethyl Acetate Fraction
2.3. Biological Activities of Cliona sp. Total Extract (CT), n-Hexane (CH), Dichloromethane (CD) and Ethyl Acetate (CE) Fractions
2.3.1. Antimicrobial activity and MIC *
2.3.2. Antioxidant Activity
2.3.3. Cytotoxic Activity
3. Materials and Methods
3.1. General Materials and Methods
3.2. Collection of Marine Sponge Samples
3.3. Extraction and Fractionation of Cliona sp.
3.3.1. Isolation of Compounds 1 and 2 from n-Hexane Soluble Fraction of Cliona sp.
3.3.2. Isolation of Compound 3 from Dichloromethane Soluble Fraction of Cliona sp.
3.3.3. Isolation of Compound 4 from Ethyl Acetate Soluble Fraction of Cliona sp.
3.3.4. Compounds 1 & 2 (Coprostanol & Brassicasterol)
3.3.5. Compound 3 (Stigmasterol)
3.3.6. Compounds 4 (Taurine)
3.4. UPLC-ESI-MS/MS Analysis and Separation Method of Cliona sp. Extract and Its Fractions
3.5. GC-MS Analysis of Compounds 1 & 2
3.6. Biological Activities
3.6.1. Antioxidant Activity
3.6.2. Cytotoxic Activity
3.6.3. Antimicrobial Activity
Minimum Inhibitory Concentration Determination (MIC)
3.7. Statistical Analysis
4. Conclusions
Supplementary Materials
Author Contributions
Funding
Institutional Review Board Statement
Informed Consent Statement
Data Availability Statement
Acknowledgments
Conflicts of Interest
References
- El-Hossary, E.M.; Abdel-Halim, M.; Ibrahim, E.S.; Pimentel-Elardo, S.M.; Nodwell, J.R.; Handoussa, H.; Abdelwahab, M.F.; Holzgrabe, U.; Abdelmohsen, U.R. Natural products repertoire of the Red Sea. Mar. Drugs 2020, 18, 457. [Google Scholar] [CrossRef]
- Abou El-Ezz, R.; Ibrahim, A.; Habib, E.; Kamel, H.; Afifi, M.; Hassanean, H.; Ahmed, S. Review of natural products from marine organisms in the Red Sea. Int. J. Pharm. Sci. Res. 2017, 8, 940. [Google Scholar]
- Anjum, K.; Abbas, S.Q.; Shah, S.A.A.; Akhter, N.; Batool, S.; ul Hassan, S.S. Marine sponges as a drug treasure. Biomol. Ther 2016, 24, 347. [Google Scholar]
- Maslin, M.; Gaertner-Mazouni, N.; Debitus, C.; Joy, N.; Ho, R. Marine sponge aquaculture towards drug development: An ongoing history of technical, ecological, chemical considerations and challenges. Aquac. Rep. 2021, 21, 100813. [Google Scholar] [CrossRef]
- Musarat, A.; Nawal, M.A.M. Biological and Medicinal Importance of Sponge. In Biological Resource of Waters; Sajal, R., Ed.; IntechOpen: Rijeka, Croatia, 2018; p. 10. [Google Scholar]
- El-Damhougy, K.; El-Naggar, H.A.; Ibrahim, H.; Bashar, M.A.; Abou-Senna, F.M. Biological activities of some marine sponge extracts from Aqaba Gulf, Red Sea, Egypt. Int. J. Fish. Aquat. Sci. 2017, 5, 652–659. [Google Scholar]
- Said, A.A.E.; Mahmoud, B.K.; Attia, E.Z.; Abdelmohsen, U.R.; Fouad, M.A. Bioactive natural products from marine sponges belonging to family Hymedesmiidae. RSC adv. 2021, 11, 16179–16191. [Google Scholar]
- Chaves Fonnegra, A.; López Victoria, M.; Parra Velandia, F.; Zea, S. Chemical Ecology of The Excavating Sponges Cliona aprica, C. caribbaea, C. delitrix and C. tenuis. Bol. Invest. Mar. Cost. 2016, 34, 43–67. [Google Scholar]
- Chaves-Fonnegra, A.; Castellanos, L.; Zea, S.; Duque, C.; Rodríguez, J.; Jiménez, C. Clionapyrrolidine A, a metabolite from the encrusting and excavating sponge Cliona tenuis that kills coral tissue upon contact. J. Chem. Ecol. 2008, 34, 1565–1574. [Google Scholar] [CrossRef] [PubMed]
- Kouchaksaraee, R.M.; Li, F.; Nazemi, M.; Farimani, M.M.; Tasdemir, D. Molecular networking-guided isolation of new etzionin-type diketopiperazine hydroxamates from the persian gulf sponge Cliona celata. Mar. Drugs 2021, 19, 439. [Google Scholar] [CrossRef]
- Bary, K.; Elamraoui, B.; Bamhaoud, T. Chemical characterization of Cliona viridis: Sponge of Atlantic Moroccan Coast. Int. J. Innov. and Sci. Res. 1997, 26, 14–22. [Google Scholar]
- Fattorusso, E.; Taglialatela-Scafati, O.; Petrucci, F.; Bavestrello, G.; Calcinai, B.; Cerrano, C.; Di Meglio, P.; Ianaro, A. Polychlorinated androstanes from the burrowing sponge Cliona nigricans. Org. Lett. 2004, 6, 1633–1635. [Google Scholar] [CrossRef]
- Keyzers, R.A.; Daoust, J.; Davies-Coleman, M.T.; Soest, R.V.; Balgi, A.; Donohue, E.; Roberge, M.; Andersen, R.J. Autophagy-modulating aminosteroids isolated from the sponge Cliona celata. Org. Lett. 2008, 10, 2959–2962. [Google Scholar] [CrossRef]
- Stonard, R.J.; Andersen, R.J. Linear peptide alkaloids from the sponge Cliona celata (Grant). Celenamides C and D. Can. J. Chem. 1980, 58, 2121–2126. [Google Scholar] [CrossRef]
- Stonard, R.J.; Andersen, R.J. Celenamides A and B, linear peptide alkaloids from the sponge Cliona celata. J. Org. Chem. 1980, 45, 3687–3691. [Google Scholar] [CrossRef]
- Palermo, J.A.; Brasco, M.F.R.; Seldes, A.M. Storniamides AD: Alkaloids from a Patagonian sponge Cliona sp. Tetrahedron 1996, 52, 2727–2734. [Google Scholar] [CrossRef]
- Palermo, J.A.; Rodríguez Brasco, M.F.; Cabezas, E.; Balzaretti, V.; Seldes, A.M. Celenamide E, a tripeptide alkaloid from the Patagonian sponge Cliona chilensis. J. Nat. Prod. 1998, 61, 488–490. [Google Scholar] [CrossRef]
- Sawangwong, P.; Wattanadilok, R.; Kijjoa, A.; Silva, A.M.; Eaton, G.; Herz, W. Secondary metabolites from a marine sponge Cliona patera. Biochem. Syst. Ecol. 2008, 5, 493–496. [Google Scholar] [CrossRef]
- Al-Saleem, M.S.M.; Hassan, W.H.B.; El Sayed, Z.I.; Abdel-Aal, M.M.; Abdel-Mageed, W.M.; Abdelsalam, E.; Abdelaziz, S. Metabolic Profiling and In Vitro Assessment of the Biological Activities of the Ethyl Acetate Extract of Penicillium chrysogenum “Endozoic of Cliona sp. Marine Sponge” from the Red Sea (Egypt). Mar. Drugs 2022, 20, 326. [Google Scholar]
- Bortolomeazzi, R.; De Zan, M.; Pizzale, L.; Conte, L.S. Mass spectrometry characterization of the 5α-, 7α-, and 7β-hydroxy derivatives of β-sitosterol, campesterol, stigmasterol, and brassicasterol. J. Agric. Food Chem. 1999, 47, 3069–3074. [Google Scholar] [CrossRef]
- Felisbino, J.K.; Vieira, B.S.; de Oliveira, A.; da Silva, N.A.; Martins, C.H.; Santiago, M.B.; Munoz, R.A.; Cunha, L.; Sousa, R.M. Identification of Substances Produced by Cercospora brachiata in Absence of Light and Evaluation of Antibacterial Activity. J. Fungi 2021, 7, 680. [Google Scholar] [CrossRef]
- Matusik, J.E.; Hoskin, G.P.; Sphon, J.A. Gas chromatographic/mass spectrometric confirmation of identity of coprostanol in Mercenaria mercenaria (Bivalvia) taken from sewage-polluted water. J. Assoc. Off. Anal. Chem. 1988, 71, 994–999. [Google Scholar] [CrossRef]
- Rajavel, T.; Mohankumar, R.; Archunan, G.; Ruckmani, K.; Devi, K.P. Beta sitosterol and Daucosterol (phytosterols identified in Grewia tiliaefolia) perturbs cell cycle and induces apoptotic cell death in A549 cells. Sci. Rep. 2017, 7, 1–15. [Google Scholar]
- Akira, K.; Mitome, H.; Imachi, M.; Shida, Y.; Miyaoka, H.; Hashimoto, T. LC-NMR identification of a novel taurine-related metabolite observed in 1H NMR-based metabonomics of genetically hypertensive rats. J. Pharm. Biomed. Anal. 2010, 51, 1091–1096. [Google Scholar]
- Chaimbault, P.; Albéric, P.; Elfakir, C.; Lafosse, M. Development of an LC–MS–MS method for the quantification of taurine derivatives in marine invertebrates. Anal. Biochem. 2004, 332, 215–225. [Google Scholar]
- Piraud, M.; Vianey-Saban, C.; Petritis, K.; Elfakir, C.; Steghens, J.P.; Morla, A.; Bouchu, D. ESI-MS/MS analysis of underivatised amino acids: A new tool for the diagnosis of inherited disorders of amino acid metabolism. Fragmentation study of 79 molecules of biological interest in positive and negative ionisation mode. Rapid Commun. Mass Spectrom. 2003, 17, 1297–1311. [Google Scholar] [CrossRef]
- Feás, C.P.; Barciela-Alonso, M.; Bermejo-Barrera, P. Direct LC–ES-MS/MS determination of phthalates in physiological saline solutions. J. Chromatogr. B 2011, 879, 231–235. [Google Scholar] [CrossRef]
- Schreiber, A.; Fu, F.; Yang, O.H.-Y.; Wan, E.C.H.; Gu, L.; Leblanc, Y. In Increasing Selectivity and Confidence in Detection When Analyzing Phthalates by LC-MS/MS; SCIEX: Hatch Drive Foster City, CA, USA, 2011. [Google Scholar]
- Shaner, R.L.; Allegood, J.C.; Park, H.; Wang, E.; Kelly, S.; Haynes, C.A.; Sullards, M.C.; Merrill Jr, A.H. Quantitative analysis of sphingolipids for lipidomics using triple quadrupole and quadrupole linear ion trap mass spectrometers. J. Lipid Res. 2009, 50, 1692–1707. [Google Scholar] [CrossRef] [PubMed]
- Lv, S.; Wang, H.; Yan, Y.; Ge, M.; Guan, J. Quantification and confirmation of four aflatoxins using a LC–MS/MS QTRAP system in multiple reaction monitoring, enhanced product ion scan, and MS3 modes. Eur. J. Mass Spectrom. 2020, 26, 63–77. [Google Scholar] [CrossRef]
- Iram, W.; Anjum, T.; Iqbal, M.; Ghaffar, A.; Abbas, M.; Khan, A.M. Structural analysis and biological toxicity of aflatoxins B1 and B2 degradation products following detoxification by Ocimum basilicum and Cassia fistula aqueous extracts. Front. Microbiol. 2016, 7, 1105. [Google Scholar]
- Khayoon, W.S.; Saad, B.; Lee, T.P.; Salleh, B. High performance liquid chromatographic determination of aflatoxins in chilli, peanut and rice using silica based monolithic column. Food Chem. 2012, 133, 489–496. [Google Scholar]
- Shu, P.-Y.; Lin, C.-H. Simple and sensitive determination of citrinin in Monascus by GC-selected ion monitoring mass spectrometry. Anal. Sci. 2002, 18, 283–287. [Google Scholar] [CrossRef]
- Elkhayat, E.S.; Mohamed, G.A.; Ibrahim, S.R.M. Activity and Structure Elucidation of Ceramides. Curr. Bioact. Compd. 2012, 8, 370–409. [Google Scholar] [CrossRef]
- Lee, M.H.; Lee, G.H.; Yoo, J.S. Analysis of ceramides in cosmetics by reversed-phase liquid chromatography/electrospray ionization mass spectrometry with collision-induced dissociation. Rapid Commun. Mass Spectrom. 2003, 17, 64–75. [Google Scholar] [CrossRef]
- Jiang, K.; Gachumi, G.; Poudel, A.; Shurmer, B.; Bashi, Z.; El-Aneed, A. The establishment of tandem mass spectrometric fingerprints of phytosterols and tocopherols and the development of targeted profiling strategies in vegetable oils. J. Am. Soc. Mass Spectrom. 2019, 30, 1700–1712. [Google Scholar] [CrossRef]
- Safafar, H.; Van Wagenen, J.; Møller, P.; Jacobsen, C. Carotenoids, phenolic compounds and tocopherols contribute to the antioxidative properties of some microalgae species grown on industrial wastewater. Mar. Drugs 2015, 13, 7339–7356. [Google Scholar] [CrossRef]
- Ibrahim, S.R.; Mohamed, G.A.; Fouad, M.A.; El-Khayat, E.S.; Proksch, P. Iotrochotamides I and II: New ceramides from the Indonesian sponge Iotrochota purpurea. Nat. Prod. Res. 2009, 23, 86–92. [Google Scholar] [CrossRef] [PubMed]
- Zollo, F.; Finamore, E.; Gargiulo, D.; Riccio, R.; Minale, L. Marine sterols. Coprostanols and 4α-methyl sterols from mediterranean tunicates. Comp. Biochem. Physiol. B Comp. Biochem. 1986, 85, 559–560. [Google Scholar] [CrossRef]
- O’Donnell, V.B. Mass spectrometry analysis of oxidized phosphatidylcholine and phosphatidylethanolamine. Biochim. Biophys. Acta Mol. Cell Biol. Lipids 2011, 1811, 818–826. [Google Scholar] [CrossRef]
- Jeong, H.-C.; Kim, T.; Yang, D.-H.; Shin, K.-H. Development of a UPLC-MS/MS method for the therapeutic monitoring of L-asparaginase. Transl. Clin. Pharmacol. 2018, 26, 134. [Google Scholar] [CrossRef]
- Mistri, H.N.; Jangid, A.G.; Sanyal, M.; Shrivastav, P. Electrospray ionization LC–MS/MS validated method to quantify griseofulvin in human plasma and its application to bioequivalence study. J. Chromatogr. B Analyt. Technol. Biomed. Life Sci. 2007, 850, 318–326. [Google Scholar] [CrossRef]
- Ory, L.; Gentil, E.; Kumla, D.; Kijjoa, A.; Nazih, E.H.; Roullier, C. Detection of ergosterol using liquid chromatography/electrospray ionization mass spectrometry: Investigation of unusual in-source reactions. Rapid Commun. Mass Spectrom. 2020, 34, e8780. [Google Scholar] [CrossRef]
- Blunt, J.W.; Copp, B.R.; Hu, W.P.; Munro, M.H.; Northcote, P.T.; Prinsep, M.R. Marine natural products. Nat. Prod. Rep. 2009, 26, 170–244. [Google Scholar] [CrossRef]
- Hsu, F.-F.; Turk, J. Structural determination of sphingomyelin by tandem mass spectrometry with electrospray ionization. J. Am. Soc. Mass Spectrom. 2000, 11, 437–449. [Google Scholar] [CrossRef]
- Winarsi, H.; Yuniaty, A. Antioxidant exploration in cardamom rhizome potential as a functional food ingredient. IOP Conf. Ser. Earth Environ. Sci. 2019, 217, 012019. [Google Scholar]
- Sun, D.; Yan, Q.; Xu, X.; Shen, W.; Xu, C.; Tan, J.; Zhang, H.; Li, L.; Cheng, H. LC-MS/MS analysis and evaluation of the anti-inflammatory activity of components from BushenHuoxue decoction. Pharm. Biol. 2017, 55, 937–945. [Google Scholar] [CrossRef]
- Thiele, B.; Stein, N.; Oldiges, M.; Hofmann, D. Direct analysis of underivatized amino acids in plant extracts by LC-MS-MS. In Amino Acid Analysis; Springer: Berlin/Heidelberg, Germany, 2012; pp. 317–328. [Google Scholar]
- Choi, S.H.; Ivancic, M.; Guzei, I.A.; Gellman, S.H. Structural Characterization of Peptide Oligomers Containing (1R, 2S)-2-Aminocyclohexanecarboxylic Acid (cis-ACHC). Eur. J. Org. Chem. 2013, 2013, 3464–3469. [Google Scholar] [CrossRef]
- Nakano, Y.; Konya, Y.; Taniguchi, M.; Fukusaki, E. Development of a liquid chromatography-tandem mass spectrometry method for quantitative analysis of trace d-amino acids. J. Biosci. Bioeng. 2017, 123, 134–138. [Google Scholar] [CrossRef] [PubMed]
- Le, A.; Ng, A.; Kwan, T.; Cusmano-Ozog, K.; Cowan, T.M. A rapid, sensitive method for quantitative analysis of underivatized amino acids by liquid chromatography–tandem mass spectrometry (LC–MS/MS). J. Chromatogr. B Analyt. Technol. Biomed. Life Sci. 2014, 944, 166–174. [Google Scholar] [CrossRef] [PubMed]
- Pallerla, P.; Bhumireddy, S.R.; Lingampally, S.S.; Ragi, N.C.; Sripadi, P. ESI-MS/MS analysis of protonated N-methyl amino acids and their immonium ions. J. Mass Spectrom. 2019, 54, 761–771. [Google Scholar] [CrossRef]
- De Oliveira, A.M.; Mesquita, M.d.S.; da Silva, G.C.; de Oliveira Lima, E.; de Medeiros, P.L.; Paiva, P.M.G.; Souza, I.A.d.; Napoleão, T.H. Evaluation of toxicity and antimicrobial activity of an ethanolic extract from leaves of Morus alba L.(Moraceae). Evid.-Based Complement. Altern. Med. 2015, 2015, 513978. [Google Scholar] [CrossRef] [PubMed]
- Feng, S.; Wang, L.; Shao, P.; Sun, P.; Yang, C.S. A review on chemical and physical modifications of phytosterols and their influence on bioavailability and safety. Crit. Rev. Food Sci. Nutr. 2022, 62, 5638–5657. [Google Scholar] [CrossRef] [PubMed]
- Peters, S.; Fohmann, I.; Rudel, T.; Schubert-Unkmeir, A. A Comprehensive Review on the Interplay between Neisseria spp. and Host Sphingolipid Metabolites. Cells 2021, 10, 3201. [Google Scholar]
- Oogarah, P.N.; Ramanjooloo, A.; Rovisham, J.; Doorga, S.; Meyepa, C.; Wilhelmus, R.; Marie, P. Assessing antioxidant activity and phenolic content of marine sponges from mauritius waters. Int. J. Pharmacogn. Phytochem. Res. 2020, 12, 123–131. [Google Scholar]
- Rahman, M.A.; Dash, R.; Sohag, A.A.M.; Alam, M.; Rhim, H.; Ha, H.; Moon, I.S.; Uddin, M.J.; Hannan, M.A. Prospects of marine sterols against pathobiology of Alzheimer’s disease: Pharmacological insights and technological advances. Mar. Drugs 2021, 19, 167. [Google Scholar] [CrossRef]
- Srisawat, T.; Chumkaew, P.; Heed-Chim, W.; Sukpondma, Y.; Kanokwiroon, K. Phytochemical screening and cytotoxicity of crude extracts of Vatica diospyroides symington type LS. Trop. J. Pharm. Res. 2013, 12, 71–76. [Google Scholar]
- Zhao, L.-G. Stachydrine Inhibits the Growth of Colon Cancer by Regulating the Expression of ACTG2. Chin. Pharm. J. 2018, 24, 1077–1082. [Google Scholar]
- Wang, M.; Shu, Z.-J.; Wang, Y.; Peng, W. Stachydrine hydrochloride inhibits proliferation and induces apoptosis of breast cancer cells via inhibition of Akt and ERK pathways. Am. J. Transl. Res. 2017, 9, 1834. [Google Scholar]
- Ma, N.; Wei, F.-Q.; Guo, J. Anti tumor activity of stachydrine by inhibiting histone diacetylase enzyme in gastric cancer. Biomed. Res. 2017, 28, 802–806. [Google Scholar]
- Rathee, P.; Rathee, D.; Rathee, D.; Rathee, S. In vitro anticancer activity of stachydrine isolated from Capparis decidua on prostate cancer cell lines. Nat. Prod. Res. 2012, 26, 1737–1740. [Google Scholar] [CrossRef]
- Cheng, F.; Zhou, Y.; Wang, M.; Guo, C.; Cao, Z.; Zhang, R.; Peng, C. A review of pharmacological and pharmacokinetic properties of stachydrine. Pharmacol. Res. 2020, 155, 104755. [Google Scholar]
- Ma, N.; He, F.; Kawanokuchi, J.; Wang, G.; Yamashita, T. Taurine and Its Anticancer Functions: In Vivo and In Vitro Study. Adv. Exp. Med. Biol. 2022, 121–128. [Google Scholar] [CrossRef]
- El-Gamal, A.A.; Al-Massarani, S.M.; Shaala, L.A.; Alahdald, A.M.; Al-Said, M.S.; Ashour, A.E.; Kumar, A.; Abdel-Kader, M.S.; Abdel-Mageed, W.M.; Youssef, D.T.A. Cytotoxic Compounds from the Saudi Red Sea Sponge Xestospongia testudinaria. Mar. Drugs 2016, 14, 82. [Google Scholar] [CrossRef] [PubMed]
- Al-Massarani, S.M.; El-Gamal, A.A.; Al-Said, M.S.; Abdel-Kader, M.S.; Ashour, A.E.; Kumar, A.; Abdel-Mageed, W.M.; Al-Rehaily, A.J.; Ghabbour, H.A.; Fun, H.K. Studies on the Red Sea Sponge Haliclona sp. for its Chemical and Cytotoxic Properties. Pharmacogn. Mag. 2016, 12, 114–119. [Google Scholar] [CrossRef] [PubMed]
- Eltamany, E.E.; Radwan, M.M.; Ibrahim, A.K.; ElSohly, M.; Hassanean, H.A.; Ahmed, S.A. Antitumor metabolites from the Red Sea sponge Spheciospongia vagabunda. Planta Med. 2014, 80, PB5. [Google Scholar] [CrossRef]
- Hawas, U.W.; Abou El-Kassem, L.T.; Abdelfattah, M.S.; Elmallah, M.I.; Eid, M.A.G.; Monier, M.M.; Marimuthu, N. Cytotoxic activity of alkyl benzoate and fatty acids from the red sea sponge Hyrtios erectus. Nat. Prod. Res. 2018, 32, 1369–1374. [Google Scholar] [CrossRef] [PubMed]
- Hassan, W.H.; Abdelaziz, S.; Al Yousef, H.M. Chemical composition and biological activities of the aqueous fraction of Parkinsonea aculeata L. growing in Saudi Arabia. Arab. J. Chem. 2019, 12, 377–387. [Google Scholar] [CrossRef]
- Saeed Kotb, S.; Ayoub, I.M.; El-Moghazy, S.A.; Singab, A.N.B. Profiling the lipophilic fractions of Pithecellobium dulce bark and leaves using GC/MS and evaluation of their antioxidant, antimicrobial and cytotoxic activities. Chem. Biodivers. 2020, 17, e2000048. [Google Scholar] [CrossRef]
- Al-Yousef, H.M.; Hassan, W.H.; Abdelaziz, S.; Amina, M.; Adel, R.; El-Sayed, M.A. UPLC-ESI-MS/MS profile and antioxidant, cytotoxic, antidiabetic, and antiobesity activities of the aqueous extracts of three different Hibiscus Species. J. Chem. 2020, 2020, 1–17. [Google Scholar] [CrossRef]
- Gülcin, I.; Küfrevioglu, O.; Oktay, M.; Büyükokuroglu, M. Study of some antioxidant parameters in mice livers affected with Urtica Pilulifer extracts. J. Ethnopharmacol. 2004, 90, 205–215. [Google Scholar]
- Yen, G.C.; Duh, P.D. Scavenging effect of methanolic extracts of peanut hulls on free-radical and active-oxygen species. J. Agric. Food Chem. 1994, 42, 629–632. [Google Scholar] [CrossRef]
- Gomha, S.M.; Salah, T.A.; Abdelhamid, A.O. Synthesis, characterization, and pharmacological evaluation of some novel thiadiazoles and thiazoles incorporating pyrazole moiety as anticancer agents. Monatsh. Chem. 2015, 146, 149–158. [Google Scholar] [CrossRef]
- Mosmann, T. Rapid colorimetric assay for cellular growth and survival: Application to proliferation and cytotoxicity assays. J. Immunol. Methods 1983, 65, 55–63. [Google Scholar] [CrossRef]
- Hindler, J.; Howard, B.; Keiser, J. Antimicrobial agents and antimicrobial susceptibility testing. In Clinical and Pathogenic Microbiology, 2nd ed.; Mosby Inc.: St. Louis, MO, USA, 1994. [Google Scholar]
- Himratul-Aznita, W.H.; Mohd-Al-Faisal, N.; Fathilah, A. Determination of the percentage inhibition of diameter growth (PIDG) of Piper betle crude aqueous extract against oral Candida species. J. Med. Plant Res. 2011, 5, 878–884. [Google Scholar]
- Choudhary, M.I.; Thomsen, W.J. Bioassay Techniques for Drug Development; CRC Press: Boca Raton, FL, USA, 2001. [Google Scholar]
- Wikler, M.A. Methods for dilution antimicrobial susceptibility tests for bacteria that grow aerobically: Approved standard. CLSI (NCCLS) 2006, 26, M7–A7. [Google Scholar]
- Yoshida, T.; Jono, K.; Okonogi, K. Modified agar dilution susceptibility testing method for determining in vitro activities of antifungal agents, including azole compounds. Antimicrob. Agents Chemother. 1997, 41, 1349–1351. [Google Scholar] [CrossRef] [Green Version]
- Wayne, P. Reference method for broth dilution antifungal susceptibility testing of yeasts, approved standard. In CLSI Document M27-A2; Clinical and Laboratory Standards Institute: Wayne, PA, USA, 2002. [Google Scholar]

| No. | Compound Name | Rt (min.) | Parent Ion (m/z) | MS2 Fragments (m/z) | Area % Total | Reference |
|---|---|---|---|---|---|---|
| 1 | Asparagine | 0.48 | 133 [M + H]+ | 88, 73, 59, 44 | 2.40 | [26] |
| 2 | Asparagine isomer | 0.66 | 133 [M + H]+ | 88, 73, 59, 44 | 1.30 | [26] |
| 3 | Asparagine isomer | 0.67 | 133 [M + H]+ | 88, 73, 59, 44 | 1.20 | [26] |
| 4 | l-Serine | 0.72 | 104 [M + H]+ | 60, 59, 44 | 3.66 | [26] |
| 5 | l-Serine isomer | 0.83 | 104 [M + H]+ | 60, 59, 44 | 1.09 | [26] |
| 6 | Dibutyl Phthalate | 18.18 | 301 [M + Na]+ | 149 | 1.89 | [27,28] |
| 279 [M + H]+ | ||||||
| 7 | Sphingomyelin derivative | 27.38 | 482 [M + H]+ | 184, 124, 104, 60 | 7.62 | [29] |
| 8 | Aflatoxin G2 | 27.74 | 353 [M + H]+ | 295, 275, 257, 244 | 7.62 | [30,31,32] |
| 9 | Sphingomyelin derivative | 27.79 | 508 [M + H]+ | 184, 124, 104, 60 | 6.07 | [29] |
| 10 | Cyclopeptine | 28.08 | 282 [M + 2H]+ | 134, 120, 224, 57 | 1.89 | [33] |
| 11 | Sphingomyelin derivative | 29.07 | 511 [M + H]+ | 184, 124, 104, 60 | 22.6 | [29] |
| 12 | Dioctyl Phthalate | 29.20 | 413 [M + Na]+ | 279, 149 | 10.65 | [27,28] |
| 391 [M + H]+ | ||||||
| 13 | Sphingomyelin derivative | 29.52 | 511 [M + H]+ | 184, 124, 104, 60 | 22.6 | [29] |
| 14 | Sphingomyelin derivative | 30.65 | 525 [M + H]+ | 184, 124, 104, 60 | 8.47 | [29] |
| 15 | Sphingomyelin derivative | 31.18 | 525 [M + H]+ | 184, 124, 104, 60 | 1.29 | [29] |
| 16 | (2S,3R,4E)-2-(14´-methyl-pentadec anoylamino)-4-octadecene-l,3-diol | 31.19 | 539 [M + H]+ | 353, 282, 264, 126 | 0.74 | [34] |
| 17 | Ceramide sphingoid base d18:1 | 33.21 | 476 [M + H]+ | 329, 299, 281, 215, 126 | 0.50 | [34] |
| Fatty acid base C12:3 | ||||||
| 18 | N-heptadecanoyl sphingosine | 34.09 | 551 [M + 2H]+ | 299 | 2.69 | [35] |
| 19 | Undecylenic phytosphingosine C11:1 | 35.73 | 483 [M + H]+ | 317, 255 | 1.94 | [35] |
| 20 | α-Tocopherol | 36.77 | 431 [M + H]+ | 377, 190, 177, 149, 136, 120 | 2.04 | [36,37] |
| 21 | Docosanoyl sphingosine | 36.78 | 648 [M + H]+ | 365, 125, 97, 71 | 0.86 | [34,38] |
| Sphingoid base d22:0 | ||||||
| Fatty acid base C20:1 | ||||||
| 22 | Coprostanol * | 37.0 | 371 [M + H-H2O]+ | 22.06 | [39], | |
| 23 | Brassicasterol * | 37.43 | 399 [M + H]+ | 381 | 1.00 | [21] |
| No. | Compound Name | Rt (min.) | Parent Ion (m/z) | MS2 Fragments (m/z) | Area % Total | Reference |
|---|---|---|---|---|---|---|
| 1 | Glutamine | 0.25 | 142 [M + H]+ | 101, 56 | 5.94 | [26] |
| 2 | Taurine * | 0.37 | 127 [M + 2H] | 97, 43 | 4.90 | [46] |
| 3 | Stachydrine | 0.76 | 144 [M + H]+ | 153, 99 | 16.84 | [47] |
| 4 | Maleimide 5-oxime | 0.86 | 127 [M + H]+ | 110, 84, 82, 44 | 2.31 | [18] |
| 5 | 1-Pyrroline-5-carboxylic acid | 1.10 | 114 [M + H]+ | 69, 42 | 0.69 | [26] |
| 6 | Valine | 1.24 | 118 [M + H]+ | 100, 72, 56 | 0.28 | [48] |
| 7 | 2-Aminocylohexane carboxylic acid | 1.27 | 144 [M + H]+ | 128, 98 | 1.47 | [49] |
| 8 | Tetillapyrone | 1.39 | 243 [M + H]+ | 197, 123, 86 | 0.83 | [18] |
| 9 | Cysteine | 1.43 | 122 [M + H]+ | 104 | 3.92 | [50] |
| 10 | Stachydrine isomer | 3.02 | 144 [M + H]+ | 153, 99 | 0.37 | [47] |
| 11 | Tetillapyrone isomer | 3.24 | 485 [2M + H]+ | 243 [M + H]+, 197, 131 | 2.64 | [18] |
| 12 | Hydroxy proline | 4.28 | 132 [M + H]+ | 86, 56 | 0.83 | [51] |
| 13 | 5-Sulfo-l-cysteine | 5.02 | 202 [M + H]+ | 156 | 0.28 | [26] |
| 14 | Allo-isoleucine | 5.04 | 132 [M + H]+ | 86, 69 57.18, 41 | 2.94 | [26] |
| 15 | Isoleucine derivative | 5.05 | 216 [M + H]+ | 132, 86. | 4.22 | [26] |
| 16 | Isoleucine | 5.35 | 132 [M + H]+ | 86, 69, 41 | 2.94 | [26] |
| 17 | l-3-(3,4 Dihydroxyphenyl)-alanine (Dopa) | 6.40 | 198 [M + H]+ | 139, 111 | 0.43 | [26] |
| 18 | Glycerol ether | 6.40 | 313 [M - H]− | 227, 116 | 2.20 | [18] |
| 19 | N-methyl tryptophan derivative | 7.19 | 309 [M]+ | 219 | 2.64 | [52] |
| 20 | Glycerol ether | 7.33 | 345 [M + H]+ | 252, 201, 158 [M + H-(CH2)2-OCH3] | 0.58 | [18] |
| 21 | N-methyl tryptophan | 8.92 | 219 [M + H]+ | 188, 173, 118, 101 | 1.40 | [52] |
| 22 | N-methyl tryptophan isomer | 9.44 | 219 [M + H]+ | 188, 173, 118, 101 | 0.50 | [52] |
| 23 | Orotidine | 11.11 | 289 [M + H]+ | 270, 252, 132, 89 | 0.63 | [26] |
| 24 | Tetradehydro tetillapyrone | 12.03 | 239 [M + H]+ | 193, 113, 85 | 8.15 | [18] |
| Microorganism/Extract | Inhibition Zone (IZ mm) Diameter (Mean ± SD)/Minimum Inhibitory Concentration (MIC µg/mL) | ||||||||
|---|---|---|---|---|---|---|---|---|---|
| Gram-Positive Bacteria | Gram-Negative Bacteria | Fungi | |||||||
| Staphylococcus Aureus ATCC 5368 | Escherichia Coli ATCC 10536 | Pseudomonas aeruginosa ATCC 27853 | Candida Albicans ATCC 10231 | ||||||
| IZ | MIC | IZ | MIC | IZ | MIC | IZ | MIC | ||
| Cliona sp. | Total extract (CT) | 21 ± 0.72 | 62.5 ± 0.82 | 22 ± 0.72 | 125 ± 0.62 | - | - | 23 ± 0.92 | >3000 ± 1.7 |
| Hexane (CH) | 18 ± 0.82 | 2000 ± 1.4 | 21 ± 0.59 | >2000 ± 1.3 | - | - | 18 ± 0.63 | >3000 ± 1.2 | |
| Dichloromethane (CD) | 26 ± 0.72 | 125 ± 0.58 | 25 ± 0.42 | 125 ± 0.72 | 25 ±0.42 | 250 ± 0.92 | 28 ± 0.52 | 500 ± 0.9 | |
| Ethyl acetate (CE) | 22 ± 0.69 | 250 ± 0.88- | 23 ± 0.83 | 250 ± 0.98 | 22 ±0.62 | 500 ± 0.32 | 25 ± 0.59 | 3000 ± 0.38 | |
| Ciprofloxacin | - | 1.56 ± 1.2 | - | 3.125 ± 0.89 | - | 3.125 ± 0.24 | - | - | |
| Fluconazole | - | - | - | - | - | - | 42 ± 0.58 | 50 ± 0.24 | |
| DMSO (Solvent) | 10 | - | 10 | - | 19 | - | 12 | - | |
| Cell Line | IC50 (µg/mL) | ||||
|---|---|---|---|---|---|
| Tested Total Extract of Cliona sp. and Its Fractions | |||||
| CT | CH | CD | CE | Vinblastine Sulphate | |
| HCT-116 (Colon carcinoma) | 69.7 ± 3.41 | 58.4 ± 2.19 | 44.4 ± 2.6 | 6.11 ± 0.2 | 2.34 ± 0.28 |
| HEB-2 (Human Larynx carcinoma) | 116.5 ± 4.09 | 87.5 ± 3.75 | 82.1± 5.2 | 12.6 ± 0.9 | 6.61 ± 0.59 |
Disclaimer/Publisher’s Note: The statements, opinions and data contained in all publications are solely those of the individual author(s) and contributor(s) and not of MDPI and/or the editor(s). MDPI and/or the editor(s) disclaim responsibility for any injury to people or property resulting from any ideas, methods, instructions or products referred to in the content. |
© 2023 by the authors. Licensee MDPI, Basel, Switzerland. This article is an open access article distributed under the terms and conditions of the Creative Commons Attribution (CC BY) license (https://creativecommons.org/licenses/by/4.0/).
Share and Cite
Hassan, W.H.B.; El Sayed, Z.I.; Al-Wahaibi, L.H.; Abdel-Aal, M.M.; Abdel-Mageed, W.M.; Abdelsalam, E.; Abdelaziz, S. Metabolites Profiling and In Vitro Biological Characterization of Different Fractions of Cliona sp. Marine Sponge from the Red Sea Egypt. Molecules 2023, 28, 1643. https://doi.org/10.3390/molecules28041643
Hassan WHB, El Sayed ZI, Al-Wahaibi LH, Abdel-Aal MM, Abdel-Mageed WM, Abdelsalam E, Abdelaziz S. Metabolites Profiling and In Vitro Biological Characterization of Different Fractions of Cliona sp. Marine Sponge from the Red Sea Egypt. Molecules. 2023; 28(4):1643. https://doi.org/10.3390/molecules28041643
Chicago/Turabian StyleHassan, Wafaa H. B., Zeinab I. El Sayed, Lamya H. Al-Wahaibi, Mahmoud M. Abdel-Aal, Wael M. Abdel-Mageed, Eman Abdelsalam, and Sahar Abdelaziz. 2023. "Metabolites Profiling and In Vitro Biological Characterization of Different Fractions of Cliona sp. Marine Sponge from the Red Sea Egypt" Molecules 28, no. 4: 1643. https://doi.org/10.3390/molecules28041643
APA StyleHassan, W. H. B., El Sayed, Z. I., Al-Wahaibi, L. H., Abdel-Aal, M. M., Abdel-Mageed, W. M., Abdelsalam, E., & Abdelaziz, S. (2023). Metabolites Profiling and In Vitro Biological Characterization of Different Fractions of Cliona sp. Marine Sponge from the Red Sea Egypt. Molecules, 28(4), 1643. https://doi.org/10.3390/molecules28041643






